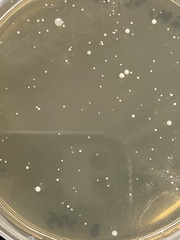
Staphylococcus aureus
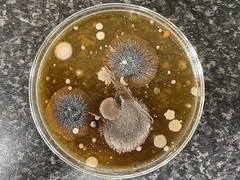
Staphylococcus aureus
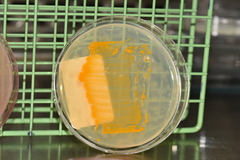
Staphylococcus aureus
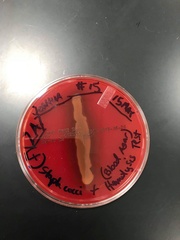
Staphylococcus aureus
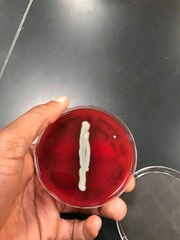
Staphylococcus aureus
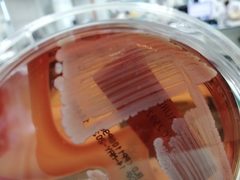
Staphylococcus aureus

©maximion, some rights reserved (CC-BY-NC)
©maximion, some rights reserved (CC-BY-NC)
©Ashwin Srinivasan, some rights reserved (CC-BY)
©Ansel Oommen, some rights reserved (CC-BY-NC)
©Sidney Alves, some rights reserved (CC-BY-SA)
©Sidney Alves, some rights reserved (CC-BY-SA)
©Sidney Alves, some rights reserved (CC-BY-SA)
©Sidney Alves, some rights reserved (CC-BY-SA)
©Sequoia Janirella Wrens, some rights reserved (CC-BY-NC)
©ryanderoo, some rights reserved (CC-BY-NC)
©ryanderoo, some rights reserved (CC-BY-NC)
©ryanderoo, some rights reserved (CC-BY-NC)
©Daniel E. Kim, some rights reserved (CC-BY-NC)
©Daniel E. Kim, some rights reserved (CC-BY-NC)
©Alan Rockefeller, some rights reserved (CC-BY)
©Heather Pickard, some rights reserved (CC-BY-NC)
©Nina Lester Finley, some rights reserved (CC-BY-NC)
©Nina Lester Finley, some rights reserved (CC-BY-NC)
©Dysprositos, some rights reserved (CC-BY-NC)
©Dysprositos, some rights reserved (CC-BY-NC)
©Simon Nicholas, some rights reserved (CC-BY-NC)
©Daniel E. Kim, some rights reserved (CC-BY-NC)
©Daniel E. Kim, some rights reserved (CC-BY-NC)
©Bobby McCabe, some rights reserved (CC-BY)
©Joshua Price, some rights reserved (CC-BY-NC)
©Joshua Price, some rights reserved (CC-BY-NC)
©aizuddinzailani, some rights reserved (CC-BY-NC)
©Karl Feng, some rights reserved (CC-BY-NC)
©Karl Feng, some rights reserved (CC-BY-NC)
©Antonios Kalogeris, some rights reserved (CC-BY-NC)
©Antonios Kalogeris, some rights reserved (CC-BY-NC)
©Antonios Kalogeris, some rights reserved (CC-BY-NC)
©Antonios Kalogeris, some rights reserved (CC-BY-NC)
©Antonios Kalogeris, some rights reserved (CC-BY-NC)
©Antonios Kalogeris, some rights reserved (CC-BY-NC)
©Antonios Kalogeris, some rights reserved (CC-BY-NC)